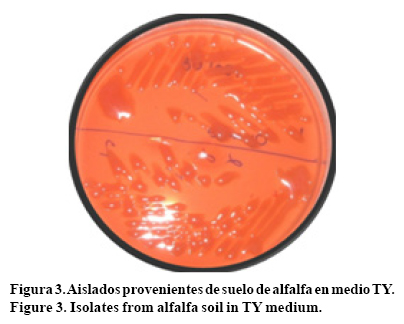

Servicios Personalizados
Revista
Articulo
Indicadores
-
Citado por SciELO -
Accesos
Links relacionados
-
Similares en
SciELO
Compartir
Revista mexicana de ciencias agrícolas
versión impresa ISSN 2007-0934
Rev. Mex. Cienc. Agríc vol.4 no.3 Texcoco abr./may. 2013
Artículos
Efecto de las prácticas agrícolas sobre las poblaciones bacterianas del suelo en sistemas de cultivo en Chihuahua, México*
Effect of agricultural practices on soil bacterial populations in cropping systems in Chihuahua, Mexico
Lina Hernández-Flores1§, J. Antonio Munive-Hernández2, Engelberto Sandoval-Castro1, Daniel Martínez-Carrera1 y Ma. Carmen Villegas-Hernández3
1Colegio de Postgraduados. Campus-Puebla. Carretera Federal México-Puebla km 125.5, Santiago Momoxpan, Municipio de San Pedro Cholula, Puebla. C. P. 72760. México Tel.: (52) 222-2852162. (engelber@colpos.mx), (dcarrera@colpos.mx). §Autora para correspondencia: hlina@colpos.mx.
2Benemérita Universidad Autónoma de Puebla, México. C. P. 72570. Tel: 52 (222) 229 55 00 - 2555. (joseantonio.munive@correo.buap.mx).
3Escuela Nacional de Ciencias Biológicas. Instituto Politécnico Nacional. Prol. Carpio y Plan de Ayala S/N 11340 México D. F. (marycarmenvm@yahoo.com).
* Recibido: julio de 2012
Aceptado: febrero de 2013
Resumen
La sustentabilidad en México es el mayor desafío que enfrenta el país ante un panorama de degradación ambiental poco alentador. El conocimiento y aplicación de opciones amigables con el medio ambiente resulta necesario para preservar y mantener los recursos naturales, siendo un factor clave para elevar la rentabilidad en la producción agrícola. En la naturaleza existe un número indeterminado de asociaciones entre poblaciones microbianas, éstas son influenciadas por factores del ambiente, físicos y químicos. En el suelo, en las raíces de las plantas, las relaciones microbianas determinan cual es la comunidad dominante o inhibida, así como aquellas que coexisten sin afectar (positiva o negativamente) a otras poblaciones. Los factores que determinan la actividad microbiana son importantes debido a la influencia que tienen en el mantenimiento de la fertilidad del suelo y la nutrición de los cultivos. Por lo anterior, se efectuó el estudio de las poblaciones bacterianas presentes en localidades con diferentes condiciones edafoclimáticas. Ello para evaluarla presencia de poblaciones bacterianas potencialmente benéficas para los cultivos de interés en la región. Inicialmente, se estimó la población bacteriana total, y la subpoblación con características del grupo rhizobia, en muestras obtenidas en tres localidades del estado de Chihuahua en junio de 2007, a partir de 11 muestras compuestas de suelos con actividad agrícola. Se evaluó la densidad de poblaciones bacterianas en niveles de 1X102 a 6.6X103 UFC g-1, valores muy bajos para suelos con actividad agrícola, sugiriendo el efecto negativo de la aplicación de agroquímicos sobre las poblaciones microbianas del suelo.
Palabras clave: agricultura sustentable, biofertilizante, rhizobia, suelo.
Abstract
Sustainability is the biggest challenge faced by Mexico against a backdrop of bleak environmental degradation. It is necessary to acquire knowledge and to implement environment-friendly alternatives in order to preserve and maintain the natural resources of the country, a key factor in improving the profitability of agricultural production. In nature there is an unknown number of associations between microbial populations, which are influenced by environmental, physical and chemical factors. Microbial relationships determine the dominant or inhibited communities that exist in the soil, in the roots of the plants, and also those that coexist without affecting (positively or negatively) other populations. The factors determining microbial activity are important because of their influence in maintaining soil fertility and crop nutrition. Therefore, this work studied the bacterial populations present in locations with different soil and climatic conditions. This in order to evaluate the presence of bacterial populations potentially beneficial for the crops of interest in the region. Initially, the total bacterial population and the subpopulation with rhizobial group characteristics were estimated in samples from three localities of the state of Chihuahua in June 2007, from 11 composite samples of agricultural soils. Bacterial population density was evaluated at levels from 1X102 to 6.6X103 UFC g-1, very low values for agricultural soils, suggesting the negative effect of pesticide application on the microbial populations of the soil.
Key words: bio-fertilizer, rhizobia, soil, sustainable agriculture.
Introducción
Resulta de gran interés restaurar la microbiota de los suelos mediante estrategias que permitan mejorar su calidad en relación a la productividad agrícola y de una manera no contaminante. El uso indiscriminado de insumos agrícolas ha alterado significativamente los constituyentes orgánicos y vivos del suelo y, con ello, el equilibrio ecológico, modificando principalmente las actividades metabólicas de las diferentes poblaciones microbianas del agroecosistema. Barea et al. (2005) señalan que la disponibilidad de nutrimentos en el suelo a través de las interacciones biológicas benéficas (sinérgicas) entre los diversos componentes que promueven los procesos ecológicos, debe ser entendida y manejada para el aprovechamiento sostenible de los suelos.
La presencia de microorganismos es un indicador que permite evaluar el beneficio de los sistemas de laboreo, así como, el mantenimiento de la fertilidad del suelo (Villarreal et al., 2000). El porcentaje más alto de microorganismos se localiza en suelos con altos contenidos de materia orgánica siendo, la mayoría, bacterias que se agrupan como aerobias, anaerobias y anaerobias facultativas.
La observación del daño ocasionado por el uso constante de agroquímicos en la agricultura donde efectuamos el estudio (Chihuahua) ha motivado el interés por mejorar el conocimiento y manejo de los cultivos, así como fomentar actividades cooperativas que se establecen en el suelo entre la microbiota y las plantas. Si bien la microfauna afecta el crecimiento de las plantas y las cadenas tróficas del suelo, es mayor el impacto de las asociaciones microbianas que interactúan entre sí, debido a que el suelo es un hábitat complejo donde un gran número de poblaciones microbianas interactúan con los diversos sustratos, estando muchas de estas poblaciones asociadas a las raíces de las plantas en la zona rizosférica (Reyes et al, 2006). En los microambientes de esta zona están asentadas poblaciones microbianas asociadas a la presencia de los exudados radicales y que participan en la formación de los microagregados rizosféricos ricos en metabolitos microbianos (Barea et al, 2005; Caesar-Ton That et al, 2007).
Los microorganismos fijadores de nitrógeno no constituyen un grupo taxonómico homogéneo, la única característica que comparten es la presencia de la enzima nitrogenasa (Zehret al., 2003; Cerna et al., 2009). Este grupo reviste gran importancia debido a las ventajas tanto ecológicas como económicas que puede proporcionar su adecuada aplicación (Daniel, 2004; Villegas y Munive, 2005; Urzúa 2005; Bhattacharjeeet al., 2009; Conget al., 2009; Weir, 2011).
Los fijadores de vida libre generan amonio para su propio uso y los fijadores de nitrógeno simbióticos, como rhizobia, fijan nitrógeno asociados a la planta hospedera y le proveen nitrógeno a cambio de carbono y de un hábitat de protección (Rueda-Puente et al, 2009).
La interacción rhizobia-leguminosa es benéfica porque constituye una alternativa al uso de fertilizantes químicos y plaguicidas, estas poblaciones bacterianas son capaces de ejercer efectos específicos sobre el crecimiento vegetal, resultado la fijación simbiótica de nitrógeno.
Cultivos como alfalfa, cacahuate, algodón, nogal, papa, chile, durazno y manzano son recursos de gran importancia económica en las localidades de Ojinaga, Casas Grandes y Delicias, entre otras. Debido al manejo inapropiado de estos suelos, la continúa degradación de los mismos por los efectos climáticos y edáficos, así como la baja disponibilidad de N y de P principalmente, y los problemas de contaminación del suelo, agua y alimentos por el uso excesivo de agroquímicos existe la gestión agrícola en términos de sostenibilidad. La evaluación de las poblaciones bacterianas pertenecientes al grupo de rhizobia, representa una posible alternativa para el manejo sostenible de estos agroecosistemas, de allí la necesidad de realizar el aislamiento a partir de los suelos y cultivos de interés en Chihuahua, y seleccionarlos como biofertilizantes potenciales en relación a su efecto en la producción vegetal.
Materiales y métodos
Muestreo de suelo
El estado de Chihuahua se localiza en el norte de México entre 25° 5' y 31° 47' latitud norte, y 103° 11' y 109° 07' longitud oeste. Las condiciones climáticas predominantes son de tipo seco, clima seco árido en 28% de la superficie estatal, con una precipitación promedio anual menor a 300 mm y temperatura máxima de 40 °C; 46% del territorio estatal es semiárido con una precipitación promedio anualde300a500 mm (CONAFOR, 2004; Núñez-López et al, 2007).
En la región oeste del Estado predomina el clima templado, con régimen de lluvias durante el verano y precipitación promedio anual de 85 0 mm. El clima e s cálido en la zona de las barrancas, con 600 mm de precipitación y una temperatura promedio que supera 18 °C durante el mes más frío (Figura 1) (CONAFOR, 2004; Núñez-López et al, 2007).
Los muestreos se efectuaron con apoyo de algunos productores que expresaron su interés por el estudio de las poblaciones bacterianas como parte de una alternativa para mejorar las condiciones de sus cultivos ante los problemas que presentan (Figura 2). Se trató de abarcar las diferentes condiciones climatológicas presentes en el estado, así como, seleccionar los cultivos económicamente más importantes del estado.
Los sitios de muestreo se encuentran ubicados de acuerdo a las coordenadas mostradas en el Cuadro 1.
El sitio de muestreo se seleccionó al azar, tomando muestras de suelo a una profundidad de 15 cm en suelos con historial de cultivo de alfalfa, algodón, cacahuate, nogal, papa, chile, durazno y manzano. Las muestras de suelo fueron puestas a secar para su conservación en refrigeración hasta su uso.
De las muestras obtenidas se integraron 11 muestras compuestas de suelo de 8 cultivos para su evaluación (Cuadro 2 y 3).

Estimación de la población bacteriana en muestras de suelo Para estimar la población bacteriana total y población de rhizobia, se contó el número de unidades formadoras de colonias (UFC) de cada una de las muestras compuestas de suelo mediante la técnica de dilución decimal seriada y siembra por el método de difusión en cajas petri (por triplicado). Los medios de cultivo utilizados fueron agar nutritivo y TY (Álvarez-Solís y Anzueto-Martínez, 2004), las cajas se incubaron a 28 °C, durante 5 días. Posteriormente, se efectuó el conteo de las colonias presentes en cada dilución.
Para la determinación de la población de rhizobia, las colonias se seleccionaron y purificaron con base en el criterio de morfología colonial característica de los rhizobia, particularmente aquellas de consistencia mucoide, aspecto húmedo, luz reflejada brillante, bordes enteros y contorno circular, así como la morfología microscópica correspondiente a bacilos Gram negativos. Igualmente, se tomo en cuenta la capacidad de absorber el colorante rojo congo del medio del cultivo, ya que algunas bacterias del grupo tienden a adsorber el colorante aplicado en el medio de cultivo. Las cepas se purificaron por resiembras consecutivas en agar TY, verificando al microscopio la pureza del cultivo mediante tinción de Gram, una vez obtenidos los cultivos puros se prepararon para conservación en glicerol a -20 °C.
Resultados y discusión
Las cepas aisladas de rhizobia presentaron un crecimiento rápido, entre 24 y 48 h.Algunas cepas mostraron baja o nula absorción del colorante rojo congo al ser incubadas en la oscuridad, formando colonias blancas y en ocasiones rosas; mientras que otras cepas absorbieron el colorante, formando colonias de color rojo oscuro. Sin embargo, algunas cepas son capaces de absorber el colorante fuertemente si la caja petri se expone a la luz por una o más horas, como por ejemplo, ciertas cepas de Sinorhizobium meliloti (Antoun, and Prévost, 2005) (Figura 3).
Las cepas de rhizobia aisladas de las diferentes regiones del estado de Chihuahua presentaron una muy baja tasa de supervivencia in vitro, obteniéndose una colección de únicamente 24 aislados provenientes de suelo de cultivos de alfalfa, cacahuate, algodón, papa, chile, durazno y manzano; provenientes de las tres localidades muestreadas. Como era de esperarse, las poblaciones más elevadas de este grupo bacteriano se obtuvieron de muestras asociadas a cultivos de alfalfa y cacahuate (plantas leguminosas asociadas simbióticamente a estas bacterias fijadoras de nitrógeno).
Haciendo un análisis de la composición química de los suelos, se puede concluir que los suelos del estado de Chihuahua son pobres en materia orgánica. Aunque considerando otros parámetros como contenido de nitrógeno y fósforo, en el caso del suelo de Casas Grandes, estos suelos resultan ser los más ricos en estos elementos. Comparando los suelos de Delicias y Ojinaga, el suelo asociado al cultivo de cacahuate en Delicias, es el más pobre de todos.
El análisis de las poblaciones bacterianas, tanto totales como rhizobiales, presentes en los diferentes cultivos en el estado de Chihuahua, se observa una diferencia significativa (p≤ 0.05) en las poblaciones bacterianas de los diferentes puntos de muestreo; es decir, entre las localidades de Ojinaga, Casas Grandes y Delicias. Observando diferencias en las poblaciones de los diferentes suelos de cultivo, más bien dependientes, ya sea del tipo de cultivo presente, o de las prácticas agrícolas que se desarrollan para cada cultivo. No depende del tipo de suelo, ya que este se repite en algunas zonas de muestreo, y la población bacteriana cambia con los sitios.
De manera general, se observaron las poblaciones bacterianas totales más elevadas tanto en suelos de cultivo de alfalfa en Ojinaga (4 x 105 UFC/gr), como en suelos de nogal de la localidad de Casas Grandes (3.8 x 105 UFC/gr); mientras que la población más pequeña se detectó en suelo de cultivo de papa, en la localidad de Delicias (4 x 103 UFC/gr) (Cuadro 4).
Se llegan a presentar ciertas diferencias significativas en la población bacteriana total entre las localidades de estudio; debido a la aplicación intensiva de agroquímicos, y en parte al tipo de laboreo y labranza aplicados en cada comunidad, lo que lleva a un cambio drástico en las poblaciones, disminuyendo la diversidad presente en los suelos (Rengel y Marschner, 2005; Khan, 2005; Khan, 2006). En el caso de la localidad de Ojinaga, las características del suelo son similares en los diferentescultivos (Cuadro 3), no observándose una diferencia significativa en las poblaciones bacterianas totales ni rhizobiales presentes, lo que indica una prevalencia del efecto de las practicas que se desarrollan en los diferentes cultivos de este lugar, por sobre el efecto que pueden causar el tipo de cultivo en si.
Al efectuar el aislamiento de las colonias con características morfológicas relacionadas con el grupo rhizobia, algunas presentaron baja tasa de supervivencia in vitro, obteniéndose una colección de 24 aislados bacterianos provenientes de suelo con cultivos de alfalfa 6 cepas, cacahuate 5 cepas, algodón 3 cepas, papa 1 cepa, chile 2 cepas, durazno 4 cepas y manzano 3 cepas.
Las bacterias fijadoras de nitrógeno tienen ventaja sobre otras bacterias en condiciones donde el nitrógeno disponible es limitante o completamente deficiente; sin embargo, también se ha encontrado que los fertilizantes nitrogenados y las prácticas de cultivo tienen efectos negativos sobre estas poblaciones, evitando la interacción microorganismo-planta, y por consiguiente, bloqueando el proceso de fijación biológica de nitrógeno (Reis et al, 2004). A pesar que la distribución de los microorganismos "fijadores de nitrógeno" no está completamente dictada por la disponibilidad de nitrógeno en el ambiente, sino que es aleatoria, y puede predecirse con base en las características del hábitat (Zehret al., 2003).
En el caso de las leguminosas, poseen la propiedad para mejorar la fertilidad de los suelos es debida a la capacidad que tienen estas de establecer una simbiosis fijadora de nitrógeno con bacterias del grupo de los rhizobia. Estas bacterias le proporcionan a las plantas una ventaja adaptativa, en condiciones donde el nitrógeno disponible es limitante o completamente deficiente, debido a la capacidad que tienen de transformar el nitrógeno atmosférico (inerte) en amoniaco (disponible para la mayoría de los seres vivos). Esta propiedad les permite su establecimiento en suelos con condiciones adversas, liberando al ambiente compuestos que pueden servir como nutrientes a la microflora del suelo, y permitiendo un mayor desarrollo de las poblaciones microbianas cerca de los sitios de desarrollo de estas plantas.
El suelo con cultivo de cacahuate no es sometido a la aplicación de agroquímicos y es muy pobre en nutrientes, lo que favorece el establecimiento de asociaciones microorganismo- planta que permiten cubrir necesidades nutrimentales como asimilación de nitrógeno a través de la FBN. Por el contrario, el cultivo de papa es fertilizado químicamente, al incrementarse el contenido de N y P en el suelo, las asociaciones simbióticas o endofíticas son desfavorecidas, ocasionando inclusive la desaparición de las poblaciones bacterianas en el suelo.
Recordemos que la papa ocupa el segundo lugar en producción hortícola, y aunque el cultivo de papa representa menos de 0.5% de la superficie agrícola del país, consume casi 20% del total de fungicidas agrícolas empleados, por lo que ocupa el primer lugar en el uso de insumos y agroquímicos que ocasionan problemas ambientales (Romero-Lima et al, 2000) y con ello la reducción de la población microbiana total y, en particular, del grupo rhizobia.
En el caso de las poblaciones de rhizobia, no se encontraron presentes cultivos de leguminosas en esta zona; sin embargo, las poblaciones de rhizobia en los suelos de cultivo de nogal presentaron valores muy elevados, lo que nos permitiría en un futuro establecer cultivos de leguminosas en esta zona, y con ello, mejorar las condiciones del suelo.
La inclinación de los productores a aplicar grandes cantidades de fertilizantes químicos, para asegurar altos rendimientos en la producción agrícola, es una iniciativa que puede ser sana desde el punto de vista económico pero no deseable desde el punto de vista ambiental, debido a que gran parte del fertilizante aplicado no es absorbido completamente por la planta (FAO, 2004; Mendoza et al, 2005; Salazar et al., 2009; Peña et al., 2010; Ledesma et al., 2010; Tapia et al., 2010), el resto se pierde por lixiviación y evaporación, afectando la calidad del agua mediante la percolación y escorrentía de nitratos y fosfatos y la calidad del aire por emisión de óxido nitroso, además de la degradación de los suelos por las prácticas de labranza intensiva que se aplican provocando erosión además de la pérdida de nutrimentos, materia orgánica y sobre todo reducción de las poblaciones bacterianas (Hernández- Rodríguez et al, 2010).
En este estudio la estimación de población bacteriana presente bajo aplicación de agroquímicos refleja que ésta se ve afectada en su sobrevivencia, ya que Reis et al. (2004) destacaron como condicionante de la mayor o menor abundancia de microorganismos benéficos en el suelo, el manejo del cultivo y la época del muestreo combinado con el tipo de planta hospedera, debido a la composición de los exudados radiculares y la relación C/N de la rizósfera. Otro factor en la detección de microorganismos es el medio de cultivo utilizado para evaluar estas poblaciones, ya que cualquier modificación de la humedad, materia orgánica o el pH del suelo, puede influir.
La evaluación de la degradación del suelo radica en que algunos aspectos son reversibles a largo plazo, como la declinación de materia orgánica, la erosión, así como la reducción y efectividad de la población del grupo rhizobia. Por lo que es de importancia que en los sectores agropecuarios y hasta el ambiental demanden un balance en la fertilidad, la conservación de la calidad ambiental y la protección de la salud humana, debido a que la falta de un diagnóstico en los suelos de los cultivos en estudio conlleva a errores en la selección y uso de agroquímicos (Baysalet al., 2008; Ngugiet al., 2008; Liuet al., 2010).
Es importante promover el uso de plantas leguminosas como parte de una estrategia de rehabilitación de las localidades de estudio. Ello obedece a los problemas que se presentan en cuanto al deterioro del suelo y al daño que han sufrido las poblaciones bacterianas benéficas, ya que la utilidad de las leguminosas comprende también la actividad de fitorremediación. Los suelos degradados se vuelven económicamente inservibles y no viables, se ha reportado que algunas leguminosas como: Acacia spirorbis, Acacia mangium, Cajanuscajan, Leucaena leucocephala, etc., tienen la capacidad de controlar la erosión debido a la arquitectura de su raíz (Dasharath y Van den Bosch, 2004), inclusive en el área de suelos degradados por minería y actividades industriales (Fournier et al., 2008).
La búsqueda de soluciones a los procesos de degradación de los suelos agrícolas, o bien a la recuperación de suelos agrícolas que se encuentran en zonas desérticas, como lo es el estado de Chihuahua, no solamente debemos enfocarnos en el empleo de plantas leguminosas. Existen, afortunadamente, una gran variedad de herramientas biológicas de las cuelas podemos hacer uso para solucionar estos problemas agrícolas en estas regiones del país. Se tienen las llamadas plantas actinorrícicas (asociadas a actinomicetos fijadores de nitrógeno), la micorriza (asociación planta-hongo, porciona mayor superficie de contacto de la planta con el suelo), y bacterias no fijadoras de nitrógeno pero estimuladoras del crecimiento vegetal mediante la producción de hormonas vegetales o que funcionan como biocontrol de patógenos (Toledo et al., 2008; Pohy Harwood, 2010; Degering et al., 2010; Yang et al., 2011).
Estudios reportados por Doran (1980), muestran que las diferencias en las poblaciones microbianas del suelo están relacionadas con los cambios en el contenido del agua, niveles de carbono orgánico, nitrógeno y pH del suelo, importantes para la supervivencia de la población microbiana. Sin embargo, las técnicas actuales de biología molecular permiten la detección y cuantificación de los microorganismos del suelo, tanto viables, como no cultivables, y permitirnos una aproximación de la población presente en un suelo determinado (Patra et al, 2006; Wertz et al, 2006).
Conclusiones
El análisis de las poblaciones bacterianas en muestras de suelo, en tres localidades del estado de Chihuahua, reflejó el efecto de las diferentes prácticas agrícolas, incluida la aplicación de fertilizante químico, observando una mayor población bacteriana en suelos con cultivo de alfalfa de Ojinaga y de nogal de la localidad de Casas Grandes, mientras que la menor población se detectó en suelo dedicado al cultivo de papa bajo aplicación de agroquímicos.
En la localidad de Ojinaga, se detectó que el uso de agroquímicos y el tipo de labranza es más intensivo, y en consecuencia las poblaciones bacterianas son menores. En cuanto a la población del grupo rhizobia, el número de UFC fue mayor en el suelo con el cultivo de cacahuate de la localidad de Delicias y menor en el suelo con el cultivo de papa de esta misma localidad.
La baja estabilidad de algunos de los aislados para su mantenimiento en cultivo puro impide evaluar plenamente la diversidad bacteriana disponible en los suelos de cultivo y limita su estudio, considerando que para asegurar la sustentabilidad de los sistemas agrícolas de la región la implementación de cultivos adecuados y el estudio de bacterias capaces de sobrevivir bajo condiciones edafoclimáticas adversas, debido a que en Chihuahua, se ha observado que el exceso de agroquímicos en la producción de cultivos agrícolas, ocasionando una ecología no saludable, por lo que la utilización de los recursos microbiológicos del suelo en los sistemas agrícolas es una alternativa eficiente para reducir el uso de fertilizantes químicos en los sistemas de producción, de manera que se permita el mantenimiento de la estructura física y química del suelo así como de su balance biológico.
Literatura citada
Álvarez-Solís, J. D. y Anzueto-Martínez, M de J. 2004. Actividad microbiana del suelo bajo diferentes sistemas de producción de maíz en los altos de Chiapas, México. Agrociencia 38:13-22. [ Links ]
Antoun, H. and Prevost, D. 2005. Ecology of plant growth promoting rhizobacteria. In: Siddiqui, Z. A. (Ed.) PGPR: Biocontroly Biofertilization. Springer, N. Y. 1-38 p. [ Links ]
Barea, J. M.; Pozo, R. Azcón, M. P. and Azcón-Aguilar, C. 2005. Microbial co-operation in the rhizosphere. J. Exp. Bot. 56(417):1761-1778. [ Links ]
Baysal, O. and ÇalişkanyÖ, Y. M. 2008. An inhibitory effect of a new Bacillus subtilis strain (EU07) against Fusarium oxysporum f. sp. radicis-lycopersici. Physiol. Mol. Plant Pathol. 73(1-3):25-32. [ Links ]
Bhattacharjee, R. B.; Singh, A. and Mukhopadhyay, S. N. 2009. Use of nitrogen-fixing bacteria as biofertiliser for non-legumes: prospects y challenges. Appl. Microbiol. Biotechnol. 80:199-209. [ Links ]
Caesar-Ton That, T. C.; Caesar, A. J.; Gaskin, J. F.; Sainju, U. M. and Busscher, W. J. 2007. Taxonomic diversity of predominant cultivable bacteria associated with microaggregates from two different agroecosystems their ability to aggregate soil in vitro. Appl. Soil Ecol. 36(1): 10-21. [ Links ]
Cerna, B. E.; Rejmankova, J.; Snyder. M. and Santruckova, H. 2009. Heterotrophic nitrogen fixation in oligotrophic tropical marshes: changes after phosphorus addition. Hydrobiologia, 627:55-65. [ Links ]
Cong, P. T.; Dang-Dung, T.; Minh-Hien, T.; Thanh-Hien, N.; Choudhury-Abu, T. M. A.; Kecske, M. L. and Kennedy, I. R. 2009. Inoculant plant growth-promoting microorganisms enhancere utilization of urea-N y grain yield of paddy rice in southern Vietnam. European J. Soil Biol. 45:52-61. [ Links ]
Comisión Nacional Forestal (CONAFOR). 2004. Estadísticas semanales de incendios forestales en Chihuahua 1990-2004. Gerencia Región VI Río Bravo. Chihuahua, Chihuahua. [ Links ]
Daniel, G. J. 2004. Infection y invasion of roots by symbiotic, nitrogen-fixing rhizobia d uring nodulation of temperatelegumes. Microbiol.Mol.Biol.Rev. 280-300. [ Links ]
Dasharath, P. L. and Van den Bosch, K. A. 2004. Grafting between model legumes demonstrates roles for roots y shoots in determining nodule type y host/rhizobia specificity. J. Exp. Bot. 56:1643-1650. [ Links ]
Degering, C.; Eggert, T.; Puls, M.; Bongaerts, J.; Evers, S.; Maurer, S. K. and Jaeger, K. E. 2010. Optimization of protease secretion in Bacillus subtilis y bacillus licheniformis by screening of homologous y heterologous signal peptides. Appl. Environ. Microbiol. 76(19):6370-6376. [ Links ]
Doran, J. W. 1980. Soil microbial y biochemical changes associates with reduce tillage. Soil Sci. Soc. Am. J. 44:765-771. [ Links ]
Organización de las Naciones Unidas para la Agricultura y la Alimentación (FAO) Roma, 2004. Uso de fertilizantes por cultivo en Argentina. Primera edición. 49 p. [ Links ]
Fournier, J.; Timmers, A. C. J.; Sieberer, B. J.; Jauneau, A.; Chabaud, M. and Barker, D. G. 2008. Mechanism of infection thread elongation in root hairs of Medicago truncatulay Dynamic interplay with associated Rhizobial colonization. Plantphysiology 148:1985-1995. [ Links ]
Hernández- Rodríguez, O. A.; Ojeda-Barrios, D. L.; López-Díaz, J. C. y Arras-Vota, A. M. 2010. Abonos orgánicos y su efecto en las propiedades físicas, químicas y biológicas del suelo. Tecnociencia Chihuahua. 4(1):1-6. [ Links ]
Khan,A. G. 2005. Role of soil microbes in the rhizospheres of plants growing on trace metal contaminated soils in phytoremediation. J. Trace Elements in Medicine Biol. 18:355-364. [ Links ]
Khan, A. G. 2006. Mycorrhizo remediation an enhanced form of phytoremediation. J. Zhejiang University Science B. 7(7):503-514. [ Links ]
Ledesma, R. L.; Solís, M. E.; Suaste, F. Ma. del P. y Rodríguez, G. Ma. F. 2010. Relación de métodos de labranza, siembra, riego y dosis de nitrógeno con el rendimiento de trigo. Rev. Mex. Cienc. Agríc. 1(1):55-63. [ Links ]
Liu, B.; Huang, L.; Buchenauery, H. and Kang, Z. 2010. Isolation y partial characterization of an antifungal protein from the endophytic Bacillussubtilis. Pesticide Biochem. Physiol. 98(2):305-311. [ Links ]
Mendoza, M. F.; Inzunza, I. M. A.; Moran, M. R.; Sánchez, C. I.; Catalán, V. E.A. y Villa, C. M. 2005. Respuesta de la sandia al acolchado plástico, fertilización, siembra directa y trasplante. Rev. Fitotec. Mex. 28(4):351-357. [ Links ]
Ngugi, H. K.; Dedej, S.; Delaplane, K. S.; Savelley, A. T. and Scherm, H. 2005. Effect of flower-applied S erenade biofungicide (Bacillus subtilis) on pollination-related variables in rabbiteye blueberry. Biol. Control 33(1):32-38. [ Links ]
Núñez- López, D.; Muñoz-Robles, C. A.; Reyes-Gómez, V. M.; Velasco- Velasco, I. and Gadsden-Esparza, H. 2007. Characterization of drought at different time scales in Chihuahua, México. Agrociencia 41(3):253-262. [ Links ]
Patra,A. K.; Abbadie, L.; Clays-Josserand, A.; Degrange, V.; Grayston, S. J. and Guillaumaud, N. 2006. Effects of management regime and plant species on the enzyme activity and genetic structure of N-fixing, denitrifying and nitrifying bacterial communities in grassland soils. Environ. Microbiol. 18:1005-1016. [ Links ]
Peña, R. A.; González, C. F. y Robles, E. F. 2010. Manejo agronómico para incrementar el rendimiento de grano y forraje en híbridos tardíos de maíz. Rev. Mex. Cienc. Agríc. 1(1):27-35. [ Links ]
Reis, F.; Silva, M.; Teixeira, K.; Urquiag, L e Reis, V. 2004. Identifição de isolados de Azospirillum amazonense asociados a Brachiariaspem diferentes épocas e condições de cultivo e produção de fitormônio pela bactéria. R. Bras. Cie. Sol. 28:103-113. [ Links ]
Rengel, Z, and Marschner, P. 2005. Nutrient availability and management in the rhizosphere: exploiting genotypic differences. New Phytol 168:305-312. [ Links ]
Reyes, I.; Valery, A. and Valduz, S. 2006. Phosphates olubilizing microorganis ms is olate d from rhizosphericy bulk soils of colonizer plants at an abandoned rock phosdphate mine. Plant Soil. 287(1-2):69-75. [ Links ]
Romero-Lima, M. del R.; Trinidad-Santos, A.; García-Espinosa, R.; y Ferrera- Cerrato, R. 2000. Producción de papa y biomasa microbiana en suelo con abonos orgánicos y minerales. Agrociencia. 34(3): 261-269. [ Links ]
Rueda- Puente, O. E.; Murillo- Amador, B.; García-Hernández, J. L.; Barrón- Hoyos, J. M.; Precio-Rangel, P.; Tarazón-Herrera, M. A. 2009. Capítulo XII: las bacterias promotoras del crecimiento vegetal como biofertilizantes en ambientes áridos-salinos. In: agricultura orgánica. Orona, C. I.; Salazar S. E.; Fortis, H. M.; Trejo, E. H.; Vázquez, V. C.; López, M. J. D.; Figueroa, V. R.; Zúñiga, T. R.; Preciado, R. P. y Chavarría, G. J. A. Gómez Palacio, Durango, México. (ISBN:978-607-00-1646-7). 259-275 pp. [ Links ]
Salazar- García, S.; Cossio- Vargas, L. E. y González- Durán, I. J. L. 2009. La fertilización de sitio específico mejoró la productividad del aguacate 'hass' en huertos sin riego. Agric. Téc. Méx. 35(4):436-445. [ Links ]
Tate lll, R. L. 1995. Soil microbiology. John Wiley y Sons, New Cork, USA. [ Links ]
Toledo, F. L.; González- López, J. and Calvo, C. 2008. Production of bioemulsifier by Bacillus subtilis, Alcaligenesfaecalisy Enterobacter species in liquid culture. Biores. Technol. 99(17):8470-8475. [ Links ]
Urzúa, H. 2005. Beneficios de la fijación simbiótica de N2 en Chile. Cien. Inv. Agr. 32(2):133-150. [ Links ]
Villarreal, A. A.; Corlay, Ch. L.; Robledo, S. E.; Álvarez, S. M. E.; Vargas, H. M. y Pérez, N. J. 2000. Poblaciones microbianas del suelo en la conversión a labranza de conservación. La edafología y sus perspectivas al siglo XXI. R. 429-43 pp. [ Links ]
Villegas, M. C. y Munive, A. 2005. Taxonomía y genética de la nodulación de los rhizobia, el grupo más importante de fijadores simbióticos de nitrógeno. Biótica. 2(1):55-106. [ Links ]
Wertz, S.; Degrange, V.; Prosser, J. I.; Poly, F.; Commeaux, C.; Freitag, T.; Guillaumaud, N. and Le Roux, X. 2006. Maintenance of soil functioning following erosion of microbial diversity. Environ. Microbiol. 8(12):2162-2169. [ Links ]
Weir, B. S. 2011. The current taxonomy of rhizobia.New Zealand rhizobia website. 445 http://www.rhizobia.co.nz/taxonomy/rhizobia.html. Last updated. [ Links ]
Yang, X. P.; Wang, S. M.; Zhang, D. W. and Zhou, L. X. 2011. Isolation y nitrogen removal characteristics of an aerobic heterotrophic nitrifying- denitrifying bacterium, Bacillus subtilis A1 Biores. Technol. 854-862. [ Links ]
Zehr, J. P.; Jenkins, B. D.; Short, S. M. and Steward, G. F. 2003. Nitrogenase gene diversity y microbial community structure: across-system comparison. Environ. Microbiol. 5:539-554. [ Links ]













